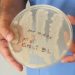
“Doğru yıkanmayan el, ölüme götürebilir!”

İzmir’de geçen yılın Kasım ayında löseminin nadir görülen tipi Juvenil Miyelomonositik Lösemi JMML teşhisi koyulan Başakşehir escort Hikaye Arin için anne Hareket Şen Yazıcı ve baba Çağdaş Yazıcı tarafından ‘Öykü Arin’e umut ol donör ol’ kampanyası başlatıldı
Medical Park Antalya Hastanesi’nde 11 Nisan’da steril odada tedaviye alınan Bayrampaşa escort bayan Hikaye Arin’e 18 Nisan’da annesinden yarı uyumlu kök hücre nakli yapıldı Yapılan testler sonucu Hikaye’ye nakledilen iliğin tutmadığı anlaşıldı
Bunun üzerine 3 Haziran’da baba Çağdaş Yazıcı’dan yarı uyumlu kök hücre Escort Beşiktaş nakli yapıldı Geçen hafta toplumsal medya hesabından Hikaye Arin’in durumuyla ilgili açıklama yapan anne Aksiyon Şen Yazıcı babasından nakledilen iliğin yüzde 98 5 oranında tuttuğunu bugün yapılacak basın açıklamasında net bilgi verileceğini açıkladı
74 gündür steril odada kalan minik Hikaye Arin bugün birinci kez dışarı çıktı Aylar sonra birinci kere hastane dışına çıkan Hikaye Arin’i annesi Aksiyon Şen Yazıcı babası Çağdaş Yazıcı ve yakınları yalnız bırakmadı Falezler kıyısında ailesiyle fotoğraf çektiren Hikaye Arin için hekimleri bugün açıklama yapacak
ÖYKÜ ARİN’İN TEDAVİSİNDE KRİTİK PERİYOT VİDEO